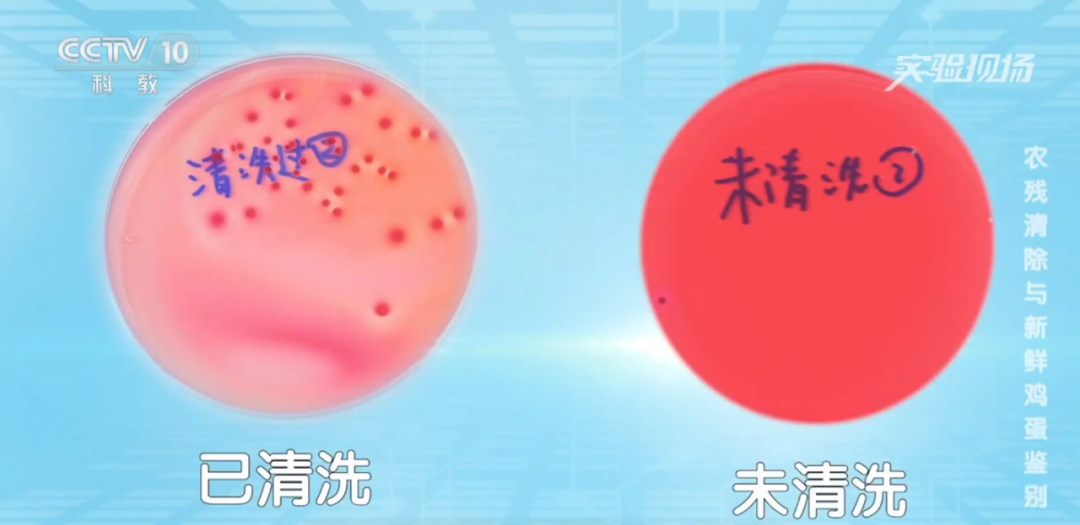
91456b1e1784736572d6ab28e6a5dc44.png 91456b1e1784736572d6ab28e6a5dc44.png

一颗蛋放倒一家人?洗蛋 vs 不洗蛋,哪个菌更多?
文章来源:东莞疾控
发布日期:2025年09月18日
浏览次数:
字体:[大][中][小]
买回鸡蛋,看着蛋壳上的点点污渍,你的第一反应是不是冲向水龙头,把它洗得干干净净再放进冰箱?如果你点头了,那么危险可能已经被你请进了家门。

前段时间,沈阳一家三口就因为这一习惯中招了 —— 把洗过的鸡蛋放冰箱几天,炒着吃后全家上吐下泻。结果查出是鸡蛋变质,滋生大量细菌所致!


今天,我们就来聊一聊关于鸡蛋储存的那些事儿,怎样才让吃蛋更安全?
隐藏在鸡蛋上的致病菌
母鸡产蛋和排泄共用一个通道,这种生理构造决定了鸡蛋和鸡屎总是会相遇的。虽然没有鸡屎的鸡蛋看起来很干净,但仍然可能会携带一些我们肉眼看不到的脏东西——致病菌。

图源:网络
有调查显示:蛋壳表面的总细菌数量约达一百五十万个。虽然这个数据听起来很吓人,但也不用太害怕。其实细菌存在于各种环境中,我们人体每平方厘米也可能有一万至一百万个细菌。
需要我们警惕的是鸡蛋中“最脏”的致病菌:包括金黄色葡萄球菌、大肠杆菌和沙门氏菌。
曾经有研究对北京市房山区、海淀区和顺义区三个地区的市售鸡蛋做了检测,结果发现:3个地区的鸡蛋蛋壳上大肠杆菌检出率较高,平均带菌率为80%;沙门氏菌平均带菌率为15%;金黄色葡萄球菌平均带菌率为5%。
通常,蛋壳表面有较明显粪便和污物的鸡蛋能检测到沙门氏菌和大肠杆菌,且细菌数较多,蛋壳表面比较干净的鸡蛋检测到的多为大肠杆菌,细菌数较少。
别洗!洗了反而 “引菌进门”
既然鸡蛋上有这么多细菌,很多人会觉得 “洗干净才卫生”,但事实却是 “越洗越脏”!关键就在蛋壳外一层看不见的 “保护盾”——天然胶质膜。
你以为蛋壳是实心的?其实它布满了肉眼看不见的小孔,就像鸡蛋的 “呼吸通道”。而这层胶质膜就像 “防尘网”:一方面能挡住外界的沙门氏菌、大肠杆菌,不让细菌钻进蛋里;另一方面还能锁住鸡蛋里的水分,让鸡蛋保持新鲜。

图源:网络
咱们自己在家洗鸡蛋,很容易冲掉这层膜。失去保护的鸡蛋,就像没关窗的房子, 细菌会顺着小孔钻进蛋内,蛋里的水分也会一个劲往外漏。放冰箱没几天,鸡蛋就可能变质。吃了变质鸡蛋会引发食品安全事件。央视实验显示:洗过的鸡蛋里面的细菌数是没洗的3~4倍!

图源:网络
有人会说:“超市的鸡蛋看着都干干净净,不是洗过吗?” 这还真不一样!商家是用专业工艺清洗,严格控制水温避免破坏膜,洗完还要喷一层食品级矿物油 “补膜”,阻挡微生物进入蛋内,和咱们在家用凉水冲完全是两码事。
“可生食无菌蛋” 真的无菌吗
现在超市里的 “无菌蛋” 卖得越来越火,价格比普通鸡蛋贵好几倍。但它真的是无菌吗?生吃更有营养吗?
误区1:“无菌蛋就是完全没细菌”。
母鸡产蛋和排泄共用一个通道,这种生理构造决定了它下不出 “绝对无菌” 的蛋。市面上所谓的无菌蛋,一般指经过巴氏杀菌以及严格加工处理过的鸡蛋,大多只保证 “没有沙门氏菌”,但还可能藏着大肠杆菌、空肠弯曲菌等致病菌。而且无菌蛋也不是在无菌的环境下运输储存,还存在二次污染的可能性,因此称其为“少菌蛋”更合适。
误区2:“生吃无菌蛋更有营养”。
恰恰相反!有研究显示,水煮蛋中91%的蛋白质可被人体吸收,而生吃的话,这个数值约为55%。因为生鸡蛋含有一些蛋白酶抑制剂,会影响蛋白质的消化吸收。此外,生吃鸡蛋还会影响人体对B族维生素的吸收。从营养价值来说,在鸡蛋最“值钱”的三样(优质蛋白、维生素、矿物质)上,“无菌蛋”与普通鸡蛋相差无几,因此没必要过度追求“无菌蛋”。
安全吃鸡蛋记住这几点
1
购买鸡蛋
2
非必要不洗蛋
一般情况下,买来的鸡蛋不需要清洗,但如果鸡蛋表面有实在难以接受的粪便污染,可以用抹布轻轻擦拭再存放在密封的鸡蛋盒中。
3
正确保存鸡蛋
买回家之后可将鸡蛋放在阴凉干燥处保存,最好放在冰箱冷藏,并注意和蔬果、肉、剩菜等分开存放,避免交叉污染。
需要注意的是,已经冷藏过的鸡蛋应继续保持在冷藏的温度,不要把之前冷藏的鸡蛋转移到室温下保存。因为温差的作用,会在蛋壳上形成水珠,可能有利于微生物进入蛋内,使鸡蛋容易变质。
4
保存时间不要太久
一次别买太多鸡蛋,少买勤买为佳,避免储存时间太久。虽然鸡蛋的表面有保护膜,但随着存放时间越来越长,这层保护膜对鸡蛋的保护能力会越来越弱。并且,鸡蛋储存时间越长,其内部会更容易被沙门氏菌污染,一般建议储存时间一个月以内为宜。
图源:网络
鸡蛋这东西,不洗才是真“干净”!下次可别再给它“洗白白”啦,否则它分分钟给你表演一个“细菌孵蛋”。
从今天起,做个聪明的“蛋主”:不瞎洗、冷藏放、早点吃。守护好鸡蛋的保护膜,也守护好全家人的健康!
祝大家吃蛋快乐,永远不“蛋”惊受怕!


无障碍浏览
长者浏览助手


